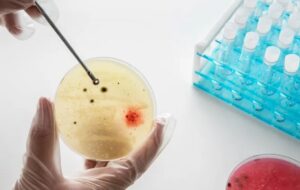
Biyomühendisler Doku Rejenerasyonu İçin Hücresel Ürünler Üretecek

Bu Ucuz Metal, Daha Güçlü ve Sağlıklı Ürünler Yetiştirmenin Anahtarı Olabilir
Bu Ucuz Metal, Daha Güçlü ve Sağlıklı Ürünler Yetiştirmenin Anahtarı Olabilir Birçok ülke, bitki büyümesini desteklemek için gübrelere nadir toprak

Bu Ucuz Metal, Daha Güçlü ve Sağlıklı Ürünler Yetiştirmenin Anahtarı Olabilir Birçok ülke, bitki büyümesini desteklemek için gübrelere nadir toprak

Kişisel Bakım Ürünlerinde Kansere Neden Olan Kimyasallar Keşfedildi Yeni bir araştırma, siyahi ve Latin kadınlar tarafından yaygın olarak kullanılan losyon,
Biyomühendisler Doku Rejenerasyonu İçin Hücresel Ürünler Üretecek Rus bilim insanları, gelişmiş rejeneratif tıp teknolojilerinin temelini oluşturacak biyomedikal hücresel ürünlerin (BICP)

Bu Plastik Ürünlere Dikkat! Metabolizmayı Bozup Kilo Almaya Sebep Olabilirler Onları hayatımızdan çıkarmak çok zor ve neredeyse hemen her gün
Pestisitli limonlar Türklere mi yediriliyor? 164 ton limona ne oldu? Pestisitli limonlar Türklere mi yediriliyor? Azınlıkça-Batı Trakya Haber isimli internet
GDO’lu ürünlerin beklenmedik etkisi Bugüne dek genetiği değiştirilmiş organizmaların (GDO) tarımda kullanılması üzerine yapılan en geniş kapsamlı araştırma tamamlandı. Virginia